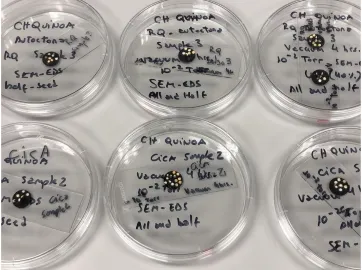
PAMELA SUCH semillas de quinoa analizadas en camaara de vacio y laser.jpeg

Entre el boom de los recursos minerales
y la exploración espacial

PAMELA SUCH *
Hace un tiempo escribí en LinkedIn un artículo que se titulaba: “Because Astronauts also have to eat” (“Porque los astronautas también tienen que comer”). La idea detrás de esa frase era simple y, al mismo tiempo, poderosa: no importa cuán lejos llegue la humanidad, cuán avanzadas sean sus naves o cuán sofisticados sus sistemas de propulsión, al final del día, incluso en una estación espacial o en un hábitat en la Luna o Marte, sigue existiendo una necesidad básica, vital e ineludible: alimentarse.
Esa reflexión inspirada por la mineria, fue le disparador que me llevo a repensar el futuro papel del campo argentino en el espacio. Porque la minería, en última instancia, cumple un rol similar. Es la fuente primaria de los recursos que alimentan nuestras sociedades modernas: sin cobre no hay electricidad, sin litio no hay transición energética, sin tierras raras no hay imanes ni turbinas, sin hierro no hay estructuras, sin oro no hay sistemas de seguridad financiera.


Si en el espacio la pregunta es cómo garantizamos alimentos, en la Tierra la pregunta es cómo garantizamos minerales críticos de forma sostenible. Y en ese interrogante aparece Argentina como un actor que no puede mirar hacia un costado: porque aquí, bajo nuestros pies, se encuentra una parte significativa del futuro energético y tecnológico del planeta.
El contexto global: hambre de minerales
El Banco Mundial, la Agencia Internacional de Energía y múltiples foros internacionales coinciden en algo: la transición energética y tecnológica demandará cantidades sin precedentes de minerales. La electrificación de la movilidad requiere litio, níquel, cobalto, grafito y manganeso. La expansión de las energías renovables (solar, eólica) depende del cobre, de las tierras raras y del aluminio. La digitalización y la inteligencia artificial consumen oro, plata, silicio, tantalio.
Un informe del World Bank estima que la producción de litio deberá multiplicarse por 40 de aquí a 2040, y la de cobalto por 20. Lo mismo ocurre con el cobre, que no solo es necesario para cables y motores, sino también para grandes redes de transmisión eléctrica.
Semillas de quinoa analizadas en camaara de vacio y laser
Estamos, entonces, frente a lo que podríamos llamar una “hambruna mineral”: el planeta entero necesita recursos, y los necesita ya. Especialmente con los nuevo desarrollos tecnologicos de IA y la necesidad de una produccion energetica sin precedentes para mantenerla.
Argentina en el mapa geológico
Argentina no es un actor secundario en este escenario. Todo lo contrario: forma parte de los grandes reservorios planetarios de minerales críticos.
+ Litio: el famoso “Triángulo del Litio” (Argentina, Chile, Bolivia) concentra alrededor del 60% de los recursos mundiales. Dentro de esa tríada, Argentina es hoy el país con mayor cantidad de proyectos en desarrollo. Provincias como Catamarca, Jujuy y Salta se han transformado en epicentros globales de la conversación energética.
+ Cobre: proyectos como El Pachón, Josemaría, Taca Taca y Agua Rica prometen convertir a nuestro país en uno de los grandes jugadores del cobre en la próxima década. Glencore, Lundin y First Quantum ya han puesto sus ojos, y sus inversions, aquí.
+ Oro y plata: San Juan, Santa Cruz y La Rioja mantienen activos proyectos de escala mundial.
+ Tierras raras y uranio: poco explorados aún, pero con potencial enorme en provincias como Mendoza, Neuquén y Chubut.
Argentina, en definitiva, no es solo “el país del litio”: es un territorio con un portafolio geológico diversificado que, bien gestionado, puede posicionarnos como un hub estratégico para la industria global.

Cámara de vacío por dentro
La oportunidad: tres caminos posibles
La pregunta que debemos hacernos es: ¿qué hacemos con esa riqueza? Existen al menos tres caminos posibles.
El camino extractivista tradicional
Consiste en dejar que grandes empresas internacionales extraigan y exporten el recurso casi en bruto, con poca participación local más allá de regalías provinciales y algunos empleos. Este modelo es rápido, simple y ha sido la norma durante décadas. Pero tiene limitaciones: baja captura de valor agregado, tensiones sociales, poca transferencia tecnológica.
El camino del valor agregado local
Aquí la clave es transformar parte de lo que se extrae en productos de mayor complejidad dentro del país: carbonato de litio a hidróxido, hidróxido a celdas, celdas a baterías, baterías a vehículos eléctricos. Lo mismo con el cobre: de concentrados a cátodos, y de cátodos a manufactura de conductores. Este modelo requiere inversión, infraestructura y estabilidad regulatoria, pero multiplica el beneficio económico. Elon Musk ya habria intentado alguna vez que SQL construya una planta de concentrado de litio en el norte de Chile sin exito, algo asi en Argentina no seria nada menor.
El camino de la innovación transversal
Implica pensar la minería no solo como extracción, sino como motor de innovación tecnológica. Por ejemplo, desarrollar en Argentina los sensores, drones, sistemas de monitoreo y software que luego pueden usarse tanto en minería local como en exploración espacial. Un ejemplo: instrumentos de análisis como LIBS o micro-XRF que hoy usamos en geología terrestre son los mismos que viajan en sondas a Marte.
Y este es el camino que yo siempre elegiria, porque es el camino de crecimiento para nuestro pais. Como ya lo definio el economista austríaco-estadonidense Joseph Schumpeter en su concepto de “destruccion creativa”: La innovacion es el motor del Desarrollo economico de un pais.
Proyectos en marcha: señales alentadoras
Los titulares de los últimos meses confirman que algo está cambiando. El Ministerio de Economía aprobó una inversión de US$ 217 millones para Galán Litio. Glencore anunció que planea producir 1 millón de toneladas de cobre en los próximos 10 a 15 años. La mina Gualcamayo proyecta US$ 665 millones para su expansión con “Carbonatos Profundos”. Son números que hablan por sí solos: Argentina está en el radar global, y los capitales ya comenzaron a desembarcar. Y las noticias de los ultimos dias “recien salidas del horno” con una inversion sin precedentes de los Estados Unidos son una puerta abierta para las empresas internacionales vengan a explorer en el pais.

Raman instrumento testeandolo en campo
El paralelismo con el espacio: innovación aplicada
Así como en mi artículo en LinkedIn hablaba de astronautas y comida, quiero extender la metáfora:
+ En el espacio, el regolito lunar es visto como fuente de oxígeno, hidrógeno y helio-3.
+ En la Tierra, el litio argentino es visto como fuente de baterías y almacenamiento de energía.
En ambos casos, el desafío no es solo extraer, sino hacerlo con tecnologías que respeten los límites del ambiente. Los instrumentos que hoy desarrollamos para minería espacial (capaces de trabajar en polvo abrasivo, con baja gravedad, sin atmósfera) tienen aplicaciones directas en minería de altura en los Andes. Argentina tiene aquí una oportunidad doble: aprovechar sus recursos y, al mismo tiempo, convertirse en semillero de tecnologías exportables al espacio y a otros países.
Mirando hacia el futuro: Argentina como “laboratorio vivo”
Imaginemos un escenario a 15 años:
+ En Catamarca, una planta de hidróxido de litio produce celdas de batería que abastecen no solo autos eléctricos, sino también satélites argentinos.
+ En San Juan, una planta de cobre transforma concentrados en cátodos y produce cables que se usan tanto en infraestructura local como en parques eólicos.
+ En Tucumán, un laboratorio de geociencias aplica inteligencia artificial a datos de exploración, desarrollando software o instrumentos para misiones espaciales (en los cuales me encuentro trabajando y ojala asi nuestro pais me preste su oido).
+ En Salta, un consorcio público-privado gestiona el agua con eficiencia, usando sistemas satelitales y sensores en tiempo real.
Ese futuro no es ciencia ficción: es posible si Argentina logra articular geología, industria, ciencia, comunidad y política en un mismo horizonte.
Educación, ciencia y tecnología: pilares olvidados
Nada de lo anterior será sostenible sin una base sólida en ciencia y educación. Necesitamos dar un salto cualitativo y actualmente me encuentro trabajando en ello: Crear centros de investigación aplicada en minería y energía. Financiar laboratorios con instrumental de última generación. Promover carreras híbridas: geociencia + inteligencia artificial, minería + robótica, química + materiales avanzados. De lo contrario, corremos el riesgo de que la minería se convierta en una isla desconectada del resto del sistema productivo.
Durnate todos mis a;os trabajando como consultora especializada para servicios mineros o cuando trabajé en el MDRU de la Universidad de British Columbia (UBC), en Vancouver, comprendí en carne propia cómo un instituto de investigación aplicada puede convertirse en una pieza clave para la industria minera global. El MDRU no solo provee análisis y servicios a proyectos en Canadá y el mundo; también forma estudiantes de posgrado, desarrolla metodologías innovadoras y establece puentes entre empresas mineras, gobiernos y universidades.
Esa experiencia me dejó una certeza: Argentina necesita un instituto comparable, adaptado a nuestras realidades y necesidades. No se trata de copiar un modelo extranjero, sino de replicar su lógica de integración: ciencia aplicada, formación de capital humano y vinculación tecnológica directa con la industria.
¿Por qué un instituto de este tipo es indispensable?
El boom minero que se avecina en Argentina (particularmente en litio y cobre) traerá consigo una demanda inédita de servicios analíticos y científicos. Hoy, gran parte de esos análisis de alta complejidad (geoquímica de trazas, isotopía, micro-Raman, micro-XRF, cartografía de elementos críticos, modelados 3D, etc.) se realizan en laboratorios en el exterior.
Esto implica tres problemas inmediatos:
+ Pérdida de soberanía científica: Dependemos de resultados generados en otros países, con tiempos y costos que no siempre se adaptan a la urgencia de los proyectos locales.
+ Fuga de divisas: Las empresas argentinas (y extranjeras que operan aquí) gastan millones de dólares al año en servicios de laboratorio fuera del país. Ese dinero podría invertirse en infraestructura local.
+ Desaprovechamiento del talento nacional: Nuestros científicos y técnicos están altamente capacitados, pero no siempre cuentan con los instrumentos y laboratorios necesarios para desplegar su potencial.
Un instituto comparable en Argentina solucionaría esos tres problemas al mismo tiempo.
Esta oportunidad no se limita a crear un laboratorio de análisis. La idea es establecer un Instituto de Innovación y Tecnologías Aplicadas a la Minería y las Geociencias, que cumpla múltiples funciones:
+ Servicios analíticos a gran escala para empresas mineras que operan en Argentina y Sudamérica (litio, cobre, oro, uranio, tierras raras).
+ Plataforma de vinculación tecnológica con el resto del pais.
+ Formación de estudiantes y profesionales, con programas de maestría y doctorado en geociencias aplicadas, minería sustentable y tecnologías instrumentales.
+ Desarrollo de innovación tecnológica, aplicando inteligencia artificial, robótica y sensórica avanzada a la exploración minera.

SEM-EDX instrument
Servicios indispensables para la nueva minería
En términos prácticos, el instituto debería contar con laboratorios de:
+ Geoquímica avanzada (ICP-MS, LA-ICP-MS, micro-XRF, LIBS).
+ Petrografía digital y micro-Raman, para caracterización de minerales en escalas micro y nano.
+ Geofísica aplicada, con estaciones sísmicas, magnetometría y equipos de modelado 3D.
+ Plataformas de IA y big data, para integrar datos geológicos y generar modelos predictivos.
+ Cámaras de simulación, que permitan probar instrumentos en condiciones análogas a ambientes de altura o incluso extraterrestres (regolito lunar, marciano).
Estos servicios no son un lujo: serán indispensables para que la minería argentina pueda competir en igualdad de condiciones con países como Canadá, Australia o Chile.
Un nodo de articulación nacional
Un aspecto fundamental es que este instituto no debe pensarse como un enclave aislado en Tucumán. Por el contrario, debe funcionar como un nodo articulador de toda la infraestructura educativa y científica del país:
+ Establecer convenios con universidades nacionales (UBA, UNC, UNLP, UNSJ, UNT).
+ Vincularse con centros del CONICET especializados en geociencias.
+ Trabajar en conjunto con CONAE para integrar información satelital a la exploración.
+ Colaborar con escuelas técnicas y politécnicos locales para formar técnicos especializados.
De esa manera, el instituto se transformaría en un motor federal de conocimiento, descentralizando capacidades y democratizando el acceso a tecnología de punta.
Impacto en el ecosistema argentino
Las ventajas de crear un instituto de este tipo serían múltiples:
+ Económicas: ahorro de divisas, generación de empleo calificado, atracción de inversiones internacionales.
+ Científicas: desarrollo de líneas de investigación propias, publicaciones de alto impacto, patentes tecnológicas.
+ Sociales: formación de jóvenes en carreras de alto valor agregado, oportunidades de desarrollo en provincias del NOA.
+ Estratégicas: autonomía tecnológica, soberanía sobre nuestros datos geológicos, capacidad de negociación frente a empresas extranjeras.
Minería espacial: del subsuelo al cosmos
La minería espacial es ya parte de la agenda internacional. El concepto de ISRU (In-Situ Resource Utilization) busca utilizar los recursos de la Luna, Marte o asteroides para sostener misiones.
+ El regolito lunar contiene oxígeno y metales.
+ Asteroides carbonáceos albergan agua y compuestos orgánicos.
+ Asteroides metálicos ofrecen hierro, níquel y platino.
Argentina tiene la oportunidad de participar en este campo, aprovechando su experiencia en minería y su talento científico.
Un JPL Argentino.
Estados Unidos cuenta con el Jet Propulsion Laboratory (JPL) y Argentina podría crear su equivalente con una misión multiple, una extension dle anterior mencionado laboratorio podria:
+ Desarrollar instrumentación para exploración espacial y terrestre.
+ Participar en programas como ARTEMIS de la NASA o las misiones lunares de la ESA.
+ Formar científicos jóvenes en proyectos internacionales.
+ Transferir tecnologías a la industria local.
Ambos laboratorios, posicionarían al país como actor relevante en minería terrestre y espacial.

Laboratorio Preparación de análogos - Colorado
Una visión de país
En última instancia, la creación de un instituto de estas características es una decisión estratégica de país. No podemos permitir que nuestros científicos o las empresas sigan mirando al extranjero para realizar análisis que perfectamente podrían hacerse aquí. Argentina tiene los recursos naturales, tiene el talento humano, tiene las universidades: lo que falta es la infraestructura y la decisión política de invertir en ella.
Un instituto de esta categoria podría convertirse en el corazón de una nueva era para la minería nacional y para el new space espacial: una era donde la ciencia, la innovación y la industria caminen juntas, generando un círculo virtuoso de desarrollo sostenible.
Pero, volviendo al titular de la nota y el articulo original, que tiene que ver el Campo en todo esto?
ARTEMIS e ISRU Lunar: la llave de la permanencia
Las misiones ARTEMIS no buscan solo volver a la Luna, sino quedarse. Para eso, la minería será clave: extraer oxígeno del regolito, agua de los cráteres polares y eventualmente producir combustibles en superficie.
Argentina, a traves de este instituto, podría aportar
+ Tecnologías analíticas para regolito.
+ Experiencia en ambientes extremos como los Andes, la Puna y el sur Argentino.
+ Modelos predictivos basados en IA.
+ Instrumentacion aplicada a la eploracion y explotacion.
Pero tambien…
Hábitats lunares y el agro argentino
Sostener un hábitat lunar implica energía, agua, protección y, sobre todo, comida. Aquí aparece un puente inesperado pero lógico: la agricultura argentina. De la cual llevamos tantos a;os de experincia y resultados postivos que llegamos a ser llamados el Granero del mundo. Argentina podria aportar:
+ Innovacion en el desarrollo de cultivos en ambientes controlados.
+ Aplicación de biotecnología en condiciones extremas.
+ Diseño de silos orbitales para almacenar granos y alimentos en la órbita lunar
La Argentina, como granero del mundo, puede convertirse también en proveedor de alimentos para el espacio. Un concepto en el que he trabajado y que publiqué en LinkedIn: la creación de silos orbitales lunares que aseguren reservas de alimentos para las futuras colonias humanas.
En Argentina, sobre todo en Tucumán, contamos con institutos esepcializados en mejoras y adaptibilidad de agrocultivos, porque no evolucionar nuestra experiencia tambien al espacio? Abriendo asi una nueva frontera economica para el agro-Argentino y para el pais.
*La doctora Pamela Such es geóloga planetaria e investigadora de trayectoria internacional en minería e instrumentación espacial aplicada a la exploración de recursos minerales. Argentina y residente en Vancouver, es científica afiliada de SETI Institute. Sus contribuciones incluyen el uso de espectroscopia LIBS–Raman y estudios de regolito como análogo lunar. Tiene experiencia en instituciones como York University, UBC, UNT, Universidad de La Serena, SETI/NASA, Angloamerican, Barrick Gold, Nevada Gold Mines entre otras, ha liderado innovaciones que integran geología avanzada con prospección espacial. Su enfoque combina la minería terrestre con soluciones estratégicas para la exploración de recursos en la Luna y asteroides. Involucrada en redes como el AMADEE‑18 del Austrian Space Forum, aporta una visión integrada de ciencia, tecnología y desarrollo regional.






















































